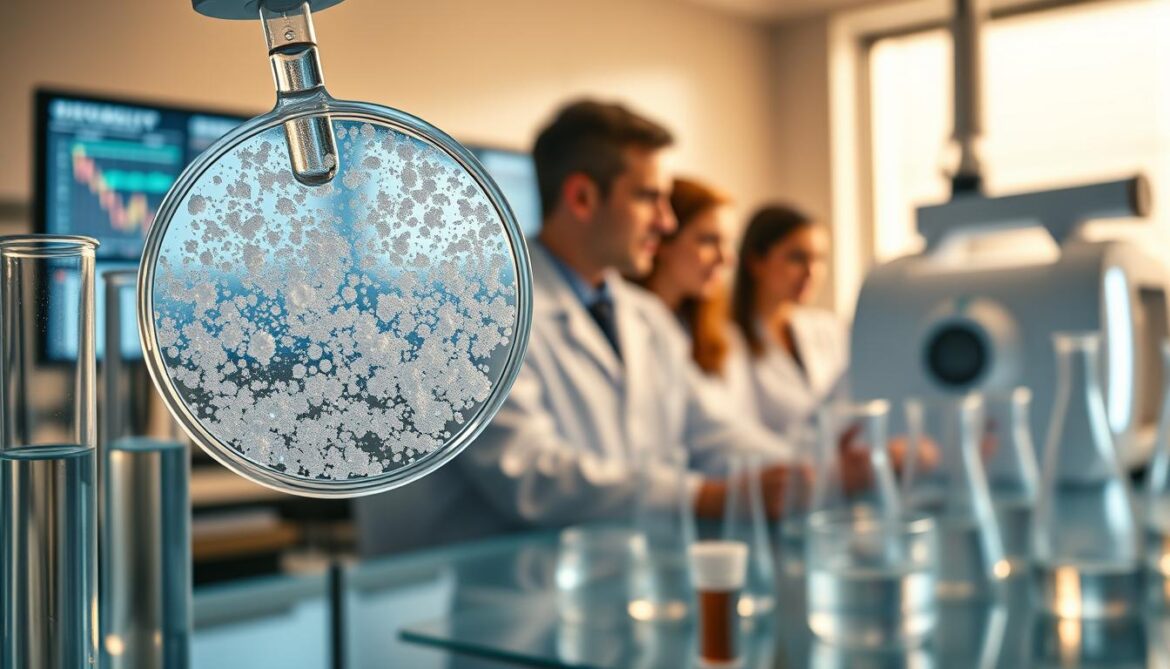
sucralose immunotherapy

Did you know 29% of people in the U.S. use artificial sweeteners like sucralose every day? This makes us wonder about its effects, like on treatments like immunotherapy.
Studies from places like the University of Pittsburgh and UPMC Hillman Cancer Center found something interesting. They think sucralose might mess with our gut’s good bacteria. This could affect how well cancer treatments like immunotherapy work.
Key Takeaways:
- Sucralose is a common artificial sweetener used by 29% of Americans daily.
- Research indicates that sucralose may impact the effectiveness of immunotherapy in treating cancers.
- Studies from prominent institutions highlight possible interference of sucralose with the gut microbiome.
- Understanding sucralose’s impact on immune function is key for cancer patients on immunotherapy.
- Ongoing research aims to clarify how sucralose affects our health in the long run.
Introduction to Sucralose
Sucralose is known as Splenda in stores. It’s a sugar substitute with no calories. This makes it great for those who want to eat less but stay sweet.
What is Sucralose?
Sucralose comes from sugar but is changed chemically. It’s 600 times sweeter than sugar. Yet, our bodies don’t break it down, so it has no calories.
How is Sucralose Made?
Making sucralose is a complex process. First, sugar is changed with chlorine. This makes it pass through our system without being used for energy. This is why some people don’t react to it.
Common Uses of Sucralose
Sucralose is in many foods and drinks because it stays stable when heated. It’s in soft drinks, baked goods, candies, and even medicines. It helps people eat less sugar. But, some might feel sick after eating it. Knowing how it’s used helps us decide if it’s right for us.
Overview of Immunotherapy
Immunotherapy is a new way to fight cancer. It uses the body’s immune system to attack cancer. This is different from old treatments like chemo and radiation.
Definition of Immunotherapy
Immunotherapy helps the body fight cancer better. It uses special substances to make the immune system stronger. These substances can be made by the body or in a lab.
Types of Immunotherapy
There are many kinds of immunotherapy. Each works in its own special way:
- Checkpoint Inhibitors: These drugs help the immune system find and kill cancer cells. They block proteins that stop immune cells from attacking.
- CAR-T Cell Therapy: This therapy changes a patient’s T cells. It makes them better at finding and killing cancer cells.
- Cancer Vaccines: Vaccines help the immune system fight cancer. They make the body attack specific cancer targets.
- Monoclonal Antibodies: These are special molecules made in a lab. They find and mark cancer cells for the immune system to destroy.
The Role of the Immune System
The immune system is key to immunotherapy working. It has cells like T lymphocytes and natural killer cells. These cells can find and kill cancer cells.
Learning about sucralose and the immune system is exciting. It could lead to new treatments. Also, thinking about sucralose in personalized medicine is very promising.
The Mechanism of Action in Immunotherapy
Immunotherapy is a new way to fight cancer. It uses the body’s immune system to attack cancer cells. This method can target cancer cells well while keeping healthy tissues safe.
How Immunotherapy Works
Immunotherapy makes the body’s defenses stronger against cancer. It uses things like monoclonal antibodies and checkpoint inhibitors. These help the immune system fight cancer cells better.
Targeting Cancer Cells
Immunotherapy can find and attack cancer cells. It trains immune cells like T-cells to know the difference between normal and cancer cells. When T-cells are ready, they destroy cancer cells but not healthy ones.
Enhancing Immune Response
Boosting the immune system is key for immunotherapy to work. It uses drugs and treatments to make the immune system stronger. This helps fight cancer cells better.
People with sucralose sensitivity might react differently to treatments. Knowing this helps make immunotherapy fit each person’s needs. This can lead to better results in cancer treatment.
Potential Impact of Sucralose on Immunotherapy
Sucralose is a sugar substitute used to cut calories. It’s sweet but might affect health, like how it could change cancer treatments. We need to look into this.
Can Sucralose Influence Immune Function?
Studies show sucralose might change how our immune system works. It could mess with the good bacteria in our gut. This might make it harder for our immune system to fight cancer.
Effects of Artificial Sweeteners on Health
Sucralose might also cause other health problems. It could lead to inflammation and change how our body works. These changes could affect how well treatments for cancer work.
Research on Sucralose and Immunotherapy
Researchers are studying how sucralose affects immunotherapy. They want to know if artificial sweeteners change how well cancer treatments work.
Current Studies Examining the Connection
Studies are looking at sucralose’s impact on the immune system. They check if sucralose changes how well immunotherapy works. The results are mixed.
Key Findings and Implications
Early findings show sucralose might help or hurt immunotherapy. Some studies say it can make treatments better. But others worry it might get in the way.
Limitations of Existing Research
There are big challenges in sucralose research. Small groups and short studies make it hard to know for sure. We need more research to understand sucralose’s long-term effects on cancer treatments.
Nutritional Considerations in Immunotherapy
Nutrition is very important for immunotherapy to work well. It helps the body respond better to treatments. Knowing which foods help and which might not is key to better health during cancer treatment.
Diet’s Role in Immune Health
Eating well keeps your immune system strong. This is important for immunotherapy to succeed. Foods rich in vitamins, minerals, and antioxidants help your body fight off sickness.
Eating fruits, vegetables, lean proteins, and whole grains is good. It makes sure your body gets what it needs to stay healthy and strong.
Foods to Support Immunotherapy
Some foods help your immune system work better. These include:
- Fruits and Vegetables: They are full of vitamins and antioxidants.
- Lean Proteins: They help repair and grow cells.
- Whole Grains: They give you energy and fiber.
- Healthy Fats: Like those in nuts, seeds, and fish, they help cells work right.
The Impact of Artificial Sweeteners
Artificial sweeteners like sucralose can be bad for your immune system. Sucralose is seen as a sugar-free option but has health concerns. It can change the good bacteria in your gut, which is important for your immune system.
Some people might be allergic to sucralose. This can cause bad reactions. It’s also important to think about sucralose safety because it might mess with your immune system’s work.

It’s a good idea to watch how much sucralose and other artificial sweeteners you eat. This is true if you’re getting immunotherapy.
Patient Perspectives on Sucralose and Immunotherapy
Patients have a lot to say about sucralose and immunotherapy. They talk about their diet challenges and worries about artificial sweeteners. Some find it hard to eat right, while others fear how sweeteners might harm their health.
Common Concerns About Artificial Sweeteners
Many patients worry about sucralose side effects during immunotherapy. They fear digestive problems and sucralose allergies. They also worry it might mess with their immune system, leading to more intolerance.
Experiences from Cancer Patients
Cancer patients on immunotherapy share their sucralose stories. Some feel mild side effects, while others say avoiding sucralose boosts their energy and eases stomach pain. Their stories show how diet affects health during treatment.
Dietary Preferences During Treatment
Diet is key for patients on immunotherapy. Many choose natural sweeteners over sucralose to avoid side effects. They aim for a diet that supports their immune system, without sucralose.
Here’s a look at what patients prefer during immunotherapy:
| Preference | Reason |
|---|---|
| Natural Sweeteners | Reduce risk of sucralose side effects |
| Organic Foods | Avoid sucralose allergies and intolerance |
| High-Fiber Diet | Support digestive health |
Approved Immunotherapies in Oncology
Cancer treatment has changed a lot with new immunotherapies. These therapies use the immune system to fight cancer better.
FDA-Approved Treatments
Many immunotherapies are now approved by the FDA. They include checkpoint inhibitors like pembrolizumab and nivolumab. These drugs help T cells fight cancer.
More treatments are coming, giving patients new hope for better health.
How Immunotherapy is Changing Cancer Care
Immunotherapy is changing how we treat cancer. It focuses on personalized treatments. Research on sucralose is important for this.
Immunotherapies like CAR-T cell therapy change a patient’s immune cells. This is a big change in how we treat cancer.
Success Rates and Future Directions
Immunotherapies have shown good results for many patients. They can help people live longer and feel better.
Future research on sucralose is exciting. It shows that diet can affect how well treatments work. Studies suggest eating less sucralose can help treatments work better.
| Immunotherapy | FDA Approval | Mechanism | Success Rate |
|---|---|---|---|
| Pembrolizumab | Yes | PD-1 Inhibitor | Varies by cancer type |
| Nivolumab | Yes | PD-1 Inhibitor | Varies by cancer type |
| CAR-T Cell Therapy | Yes | T Cell Modification | Higher in blood cancers |
Research on sucralose is key for better cancer care. The future of cancer treatment looks bright with new studies and treatments.
Expert Opinions on Artificial Sweeteners
Experts talk about sucralose and other sweeteners during cancer treatment. They say it’s key to find the right balance. This balance helps patients get better and feel good while eating.
Nutritionists’ Views on Sucralose
Nutritionists stress the need to think about sucralose health effects. Sucralose is safe for many, but some might feel sick or have other problems. It’s important to give advice that fits each person’s needs, even more so for those fighting cancer.
Oncologists’ Perspectives on Diet
Oncologists recommend a whole-food diet during immunotherapy. They say sucralose safety is mostly okay, but moderation is key. Eating foods full of nutrients helps keep the body strong and boosts the immune system.
Consensus on Artificial Sweeteners and Health
Doctors agree that artificial sweeteners, like sucralose, can be okay in small amounts. They look closely at sucralose health effects to make sure diets are good for patients. Knowing about sucralose safety and sucralose sensitivity helps patients make smart food choices when they’re sick.
Future Research Directions
Our knowledge about sucralose and immunotherapy is growing. Researchers are excited to explore new areas. They want to learn more about sucralose’s effects on cancer treatment and immune health.
What’s Next for Sucralose Studies?
Future sucralose research will look closer at how it affects the immune system. Early studies have given us some clues. But, we need to know more about how it works and its long-term effects.
Promising Areas in Immunotherapy Research
Immunotherapy is changing how we fight cancer. New research will look at how diet, like sucralose, can help. They want to see if it can make treatments work better and help patients more.
The Need for Long-Term Studies
Even with good starting points, we need long-term studies more. They will help us understand sucralose’s long-term effects on immunotherapy. This will help make better diets for those getting treatment.
Regulatory and Health Guidelines
Sucralose is a common artificial sweetener. It has raised questions about its safety and health effects. The FDA has set rules to make sure it’s safe to eat, mainly for people getting medical treatments like immunotherapy.
FDA Stance on Sucralose
The FDA carefully looked at sucralose before saying it’s safe. They say it’s okay to eat in certain amounts. This decision came after lots of research on sucralose’s safety and how it might affect health, including allergies.
Guidelines on Artificial Sweeteners in Diet
Using artificial sweeteners like sucralose in your diet needs care. The FDA has rules on how much you can eat each day. These rules help avoid risks, which is important for people with allergies or who are very sensitive to additives.
Recommendations for Patients
Patients, like those getting immunotherapy, should follow diet advice. It’s best to talk to a doctor to make a diet plan that fits your health needs, like allergies. Even though sucralose is usually safe, getting advice from a doctor is key for your health.
“Consulting with a healthcare provider ensures that your specific dietary needs, including sucralose safety concerns, are addressed appropriately.”
Myths and Facts about Sucralose
It’s important to know the truth about sucralose safety. We need to separate myths from facts. This way, we can understand what sucralose really is.
Common Misunderstandings
Many think sucralose is unsafe and causes health problems. This comes from studies that were misunderstood. Some believe it makes everyone sick, leading to sucralose intolerance.
Debunking Myths with Science
Science tells us a lot about sucralose safety. The FDA and EFSA have done many studies. They say sucralose is safe for us to eat.
Only a few people have sucralose intolerance. This is because of how their bodies digest it.

Facts Supported by Research
There’s a lot of proof that sucralose safety is true. It has been tested a lot, even for a long time. Here are some facts:
- Approved by FDA and EFSA as a safe artificial sweetener.
- It has almost no calories, which is good for weight control.
- It’s not linked to cancer, which is a big plus.
Many studies have looked at sucralose’s effects. They say it’s safe for most people. This makes scientists agree it’s okay to eat.
| Myth | Fact |
|---|---|
| Sucralose is unsafe for long-term use. | Scientific studies confirm its safety for everyday consumption within recommended limits. |
| Sucralose causes sucralose intolerance in everyone. | Only a small percentage of people experience intolerance, similar to other food sensitivities. |
| Sucralose consumption leads to cancer. | No credible study has found a link between sucralose and cancer. |
Personalizing Immunotherapy Treatments
Looking into how our own traits and choices affect our treatments is very interesting. Making these treatments fit our lives, like our diet, can make them work better. Things like artificial sweeteners, like sucralose, are key in making treatments just right for us.
Tailoring Immunotherapy for Individuals
Personalized immunotherapy looks at each person’s genes, health, and lifestyle. This way, treatments are made just for you. For instance, how you handle sucralose might change your treatment plan.
The Role of Nutrition in Personalized Medicine
What we eat affects how well our treatments work. Eating right can help our body fight off sickness better. Studies on sucralose show it’s important to know how it affects our health. Mixing our diet with our treatments makes us healthier overall.
| Factors | Impact on Immunotherapy | Considerations |
|---|---|---|
| Genetic Makeup | Personalizes treatment plans | Genetic testing may be required |
| Health Conditions | Adjusts immunotherapy protocols | Requires a full health check |
| Dietary Habits | Influences immune response | Includes sucralose use review |
Support Resources for Patients
When dealing with cancer treatments and food worries, having good resources is key. There are many places to get help, like counseling services and online groups. Here are some important resources to help you on your journey.
Counseling Services for Diet and Nutrition
Registered dietitians and nutrition counselors can give you personal advice. They help with worries about sucralose safety and allergies. They make sure your diet is good for your treatment and health. You can find them in hospitals, cancer centers, and private offices.
Online Communities for Cancer Patients
Online groups and forums are great for sharing stories and tips. They let you talk about sucralose safety and hear others’ allergy stories. Being part of a community can really help your mood during treatment.
How to Find Reliable Information
Finding true and safe health info is very important. For info on sucralose safety and allergies, check out medical journals and government health sites. It’s good to know how to spot trustworthy sources to make smart choices.
| Resource Type | Examples |
|---|---|
| Counseling Services | Registered Dietitians, Nutrition Counselors |
| Online Communities | Health Forums, Support Groups |
| Reliable Information | Medical Journals, Government Health Websites |
Conclusion: Implications for Future Studies
Sucralose and immunotherapy are linked in a complex way. This article has looked into how diet and cancer treatment connect. It shows the promise and challenges in understanding this link.
Summary of Key Takeaways
Sucralose, a common artificial sweetener, might change how our immune system works. This could affect how well immunotherapy treatments work. More research is needed to fully understand this.
Importance of Ongoing Research
Studying how diet and treatments interact is very important. We need more research to learn how sucralose affects immunotherapy. This will help doctors give better advice to patients.
Final Thoughts on Sucralose and Immunotherapy
Future studies could change what doctors tell cancer patients about food. By learning more about sucralose, doctors can give better advice. This will help patients get the best care possible.